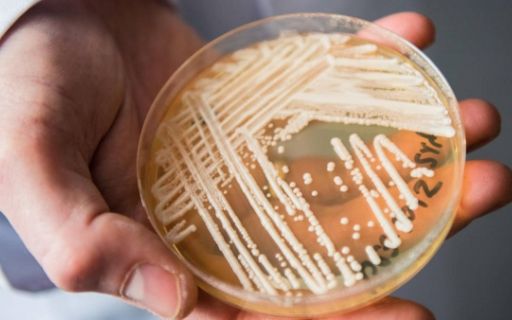

Новости науки и ИТ технологий
Специалисты в области медицины выяснили как стареют разные расы человечества склонны к разному процессу старению
Minect - новый проект украинских разработчиков, позволяющий автоматизировать процесс разминирования территорий и сделать его более безопасным.
Ученые утверждают, что на Землю надвигается разрушающая планета, которая спровоцирует апокалипсис
Метеорологи предупреждают украинских граждан о том, что прямо завтра в воздухе будет витать мощная магнитная буря
Ученые NASA выяснили, почему на планете участились землетрясения. Они считают, что причина – в отдалении Луны от Земли
Туринская плащаница все-таки может быть подлинным саваном, в который было завернуто тело Христа после его смерти
«Бесплатный сыр бывает только в мышеловке» или как не стать жертвой IT-маркетинга?
На протяжении десяти лет данные масштабных исследований по изучению влияния радиочастот, на которых работает мобильная связь, не афишировались
Новое исследование, проведенное учеными показало, что употребление 60 граммов орехов в день улучшает сексуальное желание и качество оргазма у мужчин
Глобальное потепление привело к появлению ряда новых микроорганизмов, некоторые из них несут смертельную угрозу для человечества
Расширения собирают конфиденциальную информацию о пользователях из общедоступных ссылок, предоставляемых через браузер
Космическая скала имеет диаметр до 120 метров и движется со скоростью 69 тысяч километров в час
К большому огорчению местных пожарных подразделений, огнемёты легальны в большинстве районов США
Учёные говорят, что «многообещающий» метод доставляет химиопрепараты прямо в опухоли - с меньшим количеством побочных эффектов
Уже осенью этого года выходит обновлённая версия операционной система для "яблок", и стали известны изюминки платформы
Идея о том, что наша планета на самом деле плоская - не нова, но некоторые и по сей день считают, что Земля имеет не форму сферы
Вулканологи предрекают, по крайней мере, два крупные извержения вулканов, которые могут повлиять на ход истории человечества
Ученые предупреждают, что вследствие глобального потепления может возникнуть вселенская катастрофа, связанная со всеобщим обезвоживанием планеты
Пиковая яркость красных гигантов в далеких галактиках представляет собой новый способ расчета постоянной Хаббла
Разработкой многоцелевого орбитального летательного аппарата занимаются днепровские инженеры из КБ «Южное»

Продовжуючи перегляд сайту inform-ua.info, ви підтверджуєте, що ознайомилися з
Продовжуючи перегляд сайту inform-ua.info, ви підтверджуєте, що ознайомилися з